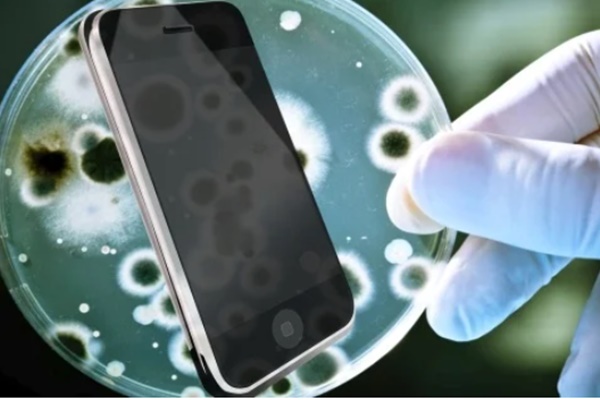
Chỉ cần 1 click biết ngay điện thoại của bạn có bị chai pin hay không-5

Bước 1
Bạn hãy sạc đầy pin điện thoại (điện thoại báo pin đầy/ vạch pin đạt 100%). Sau đó chỉnh độ sáng màn hình ở mức cao nhất và tắt hết các kết nối mạng như wifi, 3G/4G/5G. Để màn hình sáng liên tục trong vòng 60 phút.


Bước 2
Vào phần Cài đặt -> chọn Hiển thị hoặc Màn hình và độ sáng (tùy điện thoại). Tiếp tục chọn phần Ngủ (hoặc Tự động tắt màn hình) -> chọn Không bao giờ -> Chỉnh độ sáng màn hình lên cao nhất. Lưu ý, bạn phải tắt chế độ tự động chỉnh độ sáng trên điện thoại.

Sau 60 phút, nếu điện thoại của bạn còn hơn 85% pin nghĩa là pin vẫn đang rất tốt.
Theo Khoevadep